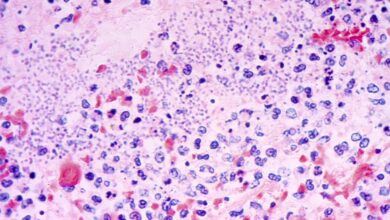
Plague kills Arizona resident, marking first recorded death since 2007, health officials say

recorded
- US News

Police claim alleged Bondi Beach gunman Naveed Akram had recorded videos outlining shooting, vowed to attack ‘Zionists’
On December 14, 2025, a tragic event unfolded at Bondi Beach in Sydney, Australia, when Naveed Akram, 24, and his…
Read More » - US News

Maryland Democratic state senator charged with extortion after feds say she recorded foe in bed with married man
A scandal has rocked the political world in Maryland as State Senator Dalya Attar, along with her brother and a…
Read More » - Health
Plague kills Arizona resident, marking first recorded death since 2007, health officials say
A tragic incident has occurred in northern Arizona, where a resident has passed away from pneumonic plague, as confirmed by…
Read More » - US News

Woman says she was raped on Coney Island and witnesses just laughed and recorded
The Fourth of July celebrations turned into a nightmare for a Brooklyn woman named Melissa Harris, who alleged that she…
Read More » - Health

Measles cases in the U.S. hit the highest total recorded in more than 30 years
The United States is currently facing a major measles outbreak, with 1,288 cases reported so far this year. This is…
Read More » - US News

Black Perceptions Of Police–Highest Confidence Levels Recorded By Gallup
The latest data indicates that Black Americans’ positive impressions of various law enforcement measures have been consistently high since 2021.…
Read More » - US News

Millions of bees have died this year. It’s “the worst bee loss in recorded history,” one beekeeper says.
The beekeeping industry in the United States is currently facing a crisis due to the alarming and unexplained deaths of…
Read More »


